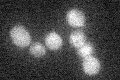
YBR245C
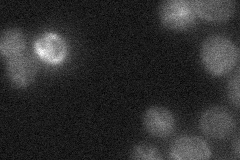
YBR245C
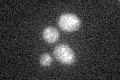
YBR245C

View description
Member of the imitation-switch (ISWI) class of ATP-dependent chromatin remodeling complexes; ATPase that forms a complex with Ioc2p and Ioc4p to regulate transcription elongation, and a complex with Ioc3p to repress transcription initiation
Localization:
Intensity:
Fold change:
Significance:
-
C’ GFP library in SD
below threshold17.88 -
N' NOP1pr-GFP in SD

nucleus55.5434 -
N' TEF2pr-mCherry in SD

nucleus20.6012 -
N' NATIVEpr-GFP in SD
below threshold17.0608 -
N' TEF2pr-VC and Cyto-VN in SD

below threshold23.4668 -
C’ GFP library in SD+DTT
cytosol13.540.75No -
C’ GFP library in SD+H2O2

cytosol20.21.12No -
C’ GFP library in Starvation Media

cytosol16.130.9No -
C’ GFP library on the background of Pup2-DaMP

below threshold -
C’ GFP library on the background of CCT mutant

below threshold16.47140.92088No
